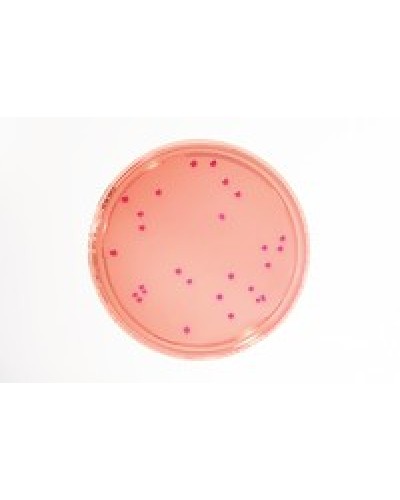
VRBD Agar - LI 30ml

VRBD Agar - LI 30ml
Code:1460000020
Hãng sản xuất: Merck
Xuất xứ: Đức
| Tên sản phẩm: | VRBD Agar - LI 30ml |
| Tên khác: | Violet Red Bile Dextrose Agar, Violet Red Bile Glucose Agar, VRBG |
| Code: | 1460000020 |
| Hãng - Xuất xứ: | Merck - Đức |
| Ứng dụng: |
- Phát hiện và liệt kê Enterobacteriaceae và vi khuẩn Gram âm dung nạp mật trong các thí nghiệm vi sinh. - Dùng làm môi trường nuôi cấy trong nghiên cứu vi sinh trong phòng thí nghiệm. |
| Tính chất: |
- Dạng rắn, màu tím đỏ - Giá trị pH: 7.4 (H₂O) |
| Bảo quản: | Tư +15°C đến +25°C |
| Quy cách đóng gói: | 20 Đĩa/ hộp |
Sản phẩm tham khảo:
| Code | Quy cách: |
| 1460000020 | 20 đĩa |
| 1460000120 | 120 đĩa |
Xu hướng tìm kiếm: VRBD Agar - LI 30ml